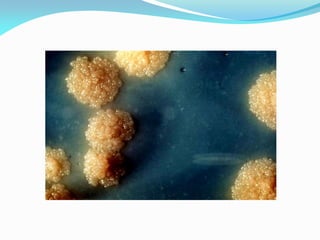

O documento discute a importância de métodos de diagnóstico para a tuberculose, enfatizando a implementação de técnicas laboratoriais no Instituto Nacional de Saúde Pública em Angola. Ele avalia a qualidade do diagnóstico laboratorial e revela uma alta taxa de resistência a antibióticos. Recomenda-se a adoção de métodos mais eficazes para a identificação das micobactérias e o uso de técnicas moleculares para melhorar a precisão do diagnóstico.